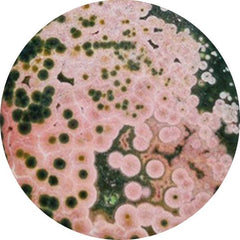

Black Onyx Pocket Druzy
GEM SPECIFICATIONS
Couldn't load pickup availability



Size & Weight
- Gems are always measured in Millimeter (mm)
- Dimensions are given as: length x width x depth (except for round stones which are: diameter x depth)
- Select gems by size, not by weight!
- Gem varieties vary in density, so carat weight is not a good indication of size.
- Note: 1ct = 0.2g






Gemstones Treatments Explained
Couldn't load pickup availability
Shipping Information
Questions about your order? Review our shipping policy.
Returns & Refunds
REFUND PROCESS:
- Refunds are processed within 3-5 business days after receiving the return
- Original payment method will be refunded
- You will receive email confirmation when refund is processed
RETURN CONDITIONS:
- Item must be in original, unworn condition
- All original packaging and certificates must be included
- Customer is responsible for return shipping costs
Not satisfied with your purchase? GFS is committed to helping you return your order easily.
Questions about your order? Review our shipping policy.
- Refunds are processed within 3-5 business days after receiving the return
- Original payment method will be refunded
- You will receive email confirmation when refund is processed
- Item must be in original, unworn condition
- All original packaging and certificates must be included
- Customer is responsible for return shipping costs
Not satisfied with your purchase? GFS is committed to helping you return your order easily.
We appreciate the value of ensuring that all gems pass through strict quality checks. And that each gem stone is tested in the quality control department after the process of crafting.
This gemstone is completely natural with no treatments or enhancements.
Yes, this gemstone is perfect for jewelry settings and custom designs.
Amethyst has a hardness of 7 on the Mohs scale, making it suitable for daily wear with proper care.
Carat weight refers to the mass of the gemstone, with one carat equal to 200 milligrams.
Our gemstones are ethically sourced from trusted suppliers around the world.
Yes, we provide certificates of authenticity for all our gemstones.
Clean with warm soapy water and a soft brush. Avoid harsh chemicals and ultrasonic cleaners.


Recent Testimonials
Customer Ratings
Quality Highlights
Customer Ratings
Also just wanted to give you feedback on my latest parcel, which arrived safely (and, again, very quickly) yesterday. I'm hugely chuffed with my selected stones and must say that those Baikal Lake Apatites in particular are utterly stunning - I totally fell in love with the material! The teal colour is my favourite anyway and the subtle chatoyance and swirly "pattern" make it absolutely beautiful. It reminds me of Pietersite a bit, which I also love. So yes, I spent a lot of time yesterday fawning over my newest batch of beauties.
Thanks again and read you again soon! 👍
I just picked up the package
This is incredible! The quality of the stones is very high, and I loved the extra gifts you added!
Thank you so much!🌷🙏
I really love the moonstones. They are so high quality 😍
I love your business. You have great stones, at good prices and you’ve always been so kind, helpful and understanding. I won’t be going anywhere.
Browse Other Trending Collections

Responsibly Sourced, Always
The GemstonesForSale Experience
When you choose GemstonesForSale, you become a valued member of our family of gemstone enthusiasts. Since our inception, we've prided ourselves on offering genuine, high-quality gemstones along with exceptional customer service — a tradition we continue to this day.
Trusted by more than 6,000 buyers across 50+ countries, our reputation has been forged through unwavering commitment to transparency, masterful craftsmanship, and an almost obsessive attention to detail. This isn't merely commerce — it's a sacred tradition we honor with every stone that passes through our hands.
performance.